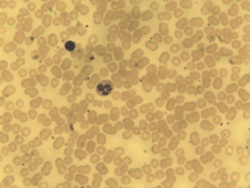
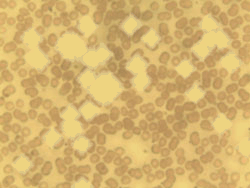

|
neuroproject.ru
Форум сайта компании НейроПроект
|
| Предыдущая тема :: Следующая тема |
| Автор |
Сообщение |
dns
Новый посетитель

Зарегистрирован: 24 Сен 2006
Сообщения: 9
|
 Добавлено: Вс Сен 24, 2006 3:59 pm Заголовок сообщения: Распознавание/классификация графических образов Добавлено: Вс Сен 24, 2006 3:59 pm Заголовок сообщения: Распознавание/классификация графических образов |
 |
|
Есть задачка по созданию программы классификации образов. Нейронками последний раз занимался очень давно.. да и мало (диплом был мой по теме лингвистического анализа и классификации текстовой информации).
Так вот, возникла пара вопросов:
1. существуют ли рекомендации по поводу того, какую из нейронок предпочтительнее для этого использовать.
2. что делать с входным изображением? (суть вопроса - ниже опишу)
Итак, на данный момент остановился на многослойной персептроне следующей конфигурации:
1. Входной поток - картинка 30х30 пикселей (т.е. 900 рецепторов будет)
2. На входном слое на каждый нейрон будет приходиться "квадратик" 2х2 пикселя (4 рецептора на один входной нейрон), итого, на первом слое будет 225 нейронов.
3. Сколько нейронов сделать на скрытом слое - не определился.
4. на выходном слое 4 нейрона.
Классификация изображений производится на 2 класса (однако внутри одного класса достаточно большая "вариабельность", в итоге - выходной слой не из 1 нейрона, а из 4х).

Смысл обработки изображения следующий - есть большая картинка (снимок анализа крови) с клеточками и мусором. Нужно клетки одного типа "выделить" из изображения и посчитать, мусор выкинуть.
Вся большая картинка бьется на участки 30х30 пикселей, как раз эти участки и будут скармливаться сети для распознавания - что на миникартинке. У тут всплывает второй вопрос - какую именно обработку этого участка необходимо произвести перед тем, как скормить сети.... или не производить? Просто - есть у нас набор байтов в матрице 30х30, где координаты матрицы = координаты пикселя, а значение элемента матрицы = значение цвета. Т.о. выстраиваем значения цвета каждого пикселя в вектор 1х900 и вперёд?
и еще один вопрос - на прямую не связанный с НС: как производить разбиение большого входного образа на участки? с отдельно-стоящей клеткой проблем нет, а вот как быть с конгломератами? когда несколько клеток слепились, и их нужно "расцепить" и каждую из них поместить в центр картинки 30х30 пикселей?
Фух... надеюсь смог донести, свои вопросы... а то пока каша в голове... с текстами по проще было... |
|
| Вернуться к началу |
|
 |
Victor G. Tsaregorodtsev
Эксперт

Зарегистрирован: 28 Июн 2005
Сообщения: 114
Откуда: Красноярск
|
 Добавлено: Вс Сен 24, 2006 5:16 pm Заголовок сообщения: Re: Распознавание/классификация графических образов Добавлено: Вс Сен 24, 2006 5:16 pm Заголовок сообщения: Re: Распознавание/классификация графических образов |
 |
|
Я бы тут нейросетки использовал в последнюю очередь.
Сначала попытка выделить нужные пятна-клетки только по яркости (интегральной или в отдельных цветовых плоскостях - r,g или b). Относительно часто работает достаточно эффективно, как ни странно. Оконтуривание объектов фильтрами, выделяющими границы на изображении, тоже можно попробовать - а дальше каждый контур грубо оценивать по размеру (для отбрасывания мелких шумов) и сопоставлять с эталонным контуром клетки через преобразование Хафа.
При неудаче - какой-нибудь хороший автосегментатор, который работает на текстурах объектов изображения, например, двумерные скрытые марковские модели.
Сетки скорее взял бы близкими к сверточным (convolutional) сетям Яна ЛеКуна вместе с его автосегментатором объектов, повешанным на сеть. Конкретно по архитектуре этих сетей (по числу слоев свертки и ресэмплинга, числу плоскостей в слоях, числу нейронов в плоскости) ничего неясно, т.к. о Ваших снимках представления не имею. Обучение, естественно, будет с учителем, на предварительно размеченных эталонных снимках.
Ваш вариант сети вряд ли будет обеспечивать хорошую инвариантность распознавания к повороту, если форма клеток отлична от круглой. Надо как-то предобрабатывать снимок для обеспечения поворотной инвариантности и трансформации контуров клетки - tangent distance и tangent prop того же ЛеКуна могут помочь добиться этого именно сеткой, без какого-то предварительного преобразования изображения (т.е. сетка будет работать именно с исходной картинкой).
Насчет распознавания конгломератов рецепт дать сложно, также как и оценить возможность настройки сверточной сети с автосегментатором под распознавание именно перекрытых друг другом объектов (с тесным соседним расположением проблем нет, сетка их разделит).
Работы ЛеКуна брать в разделе публикаций на yann.lecun.com - там Вам нужно реально посмотреть только его большую обзорную работу 98 года по распознаванию рукописных символов (вынесена наверх странички в краткий список основных результатов), и только потом при необходимости реально использовать такие нейросетки надо будет посмотреть другие процитированные в этой статье работы и работу по tangent prop. Но сразу предупреждаю, что готового софта нет и Вам придется эти сетки программировать с нуля в достаточно универсальном варианте (с возможностью управления числом слоев и т.д) для проведения экспериментов. Т.е. если возникают трудности прямо на уровне алгоритма обратного распространения ошибки для обучения многослойного персептрона, то тогда лучше и не пытаться воспроизвести эти сверточные сетки.
_________________
www.neuropro.ru - нейросети, анализ данных, прогнозирование |
|
| Вернуться к началу |
|
 |
dns
Новый посетитель

Зарегистрирован: 24 Сен 2006
Сообщения: 9
|
 Добавлено: Вс Сен 24, 2006 7:11 pm Заголовок сообщения: Re: Распознавание/классификация графических образов Добавлено: Вс Сен 24, 2006 7:11 pm Заголовок сообщения: Re: Распознавание/классификация графических образов |
 |
|
Большое спасибо за ответ!!!
| Victor G. Tsaregorodtsev писал(а): | Сначала попытка выделить нужные пятна-клетки только по яркости (интегральной или в отдельных цветовых плоскостях - r,g или b). Относительно часто работает достаточно эффективно, как ни странно.
|
была такая идея, но, по крайней мере пока, отодвинута. Причин, по которой данный метод мной был отодвинут, две:
1. в пределах одного класса клеток имеется достаточно "разброс" возможных вариантов того, как клетка будет выглядеть.
2. универсальность. При работе по яркости - мы строго привязываемся к определенному препарату, которым клетки окрашиваются (на разных препаратах разные "картинки" получаются)). Ну и под исследование попадают не только клетки человека, но и животных. Под микроскопом они по разному выглядят. Если у нас нейронка, то её можно "переобучить" на другой тип клеток, после чего "скармливать" снимки и делать обсчет... А при работе по градиенту я пока не придумал, как можно такой "гибкости в настройках" получить...
| Victor G. Tsaregorodtsev писал(а): | | При неудаче - какой-нибудь хороший автосегментатор, который работает на текстурах объектов изображения, например, двумерные скрытые марковские модели. |
а где можно про этот фильтр почитать... к своему стыду не слышал про данные модели... а яндекс что-то ничего путного не ответил ISBN или название книжки, где почитать можно...
| Victor G. Tsaregorodtsev писал(а): | | Сетки скорее взял бы близкими к сверточным (convolutional) сетям Яна ЛеКуна вместе с его автосегментатором объектов, повешанным на сеть. |
спасибо, пойду почитаю. Я тут уже немного успел Саймона Хайкина почитать про сверточные сети, но, там что то мало написано про них
| Victor G. Tsaregorodtsev писал(а): | | т.к. о Ваших снимках представления не имею. Обучение, естественно, будет с учителем, на предварительно размеченных эталонных снимках. |
это естественно а снимки... под рукой сейчас нет... надо будет еще в лабу сходить наснимать на снимках есть фон (препарат дает некцй цвет. Причем в зависимости от препарата, меняется цвет фона) и есть клеточки, которые выделяются из этого фона "обрамлением" и в некоторых случаях, внутри этого обрамления - ядро. Есть класс клеток - поразиты, которые так же надо посчитать. В этот класс попадают все клетки, которые не были отклассифицированны, как "целевые" (на которых сеть обучали).
| Victor G. Tsaregorodtsev писал(а): | | Ваш вариант сети вряд ли будет обеспечивать хорошую инвариантность распознавания к повороту, если форма клеток отлична от круглой. |
вот!!! именно по этому и решил на форуме проконсультироваться т.к. клетки располагаются в 3х мерном пространстве, то к камере они могут быть повернуты по любой из осей. В результате - обученная сетка (в моем первом посте) хорошо отрабатывает на отдельностоящих клетках и на клетках, которые очень похожи на те клетки, по которым сеть обучалась. А вот если показать сети ту же самую клетку, только повернутую на 30-40 град., то сетка "дохнет". В не повернутом варианте - клетка круглая (на снимке), в повернутом - соотв. овальная... Как раз по этому и родилась идея - использовать "предпроцессор", который будет бить изображение на секторы и внутри сектора производить некую обработку изображения, которое затем пойдет в обработку нейронкой.
| Victor G. Tsaregorodtsev писал(а): | | Насчет распознавания конгломератов рецепт дать сложно, также как и оценить возможность настройки сверточной сети с автосегментатором под распознавание именно перекрытых друг другом объектов (с тесным соседним расположением проблем нет, сетка их разделит). |
про конгломераты написал собственно как про один из возможных подводных камней...
| Victor G. Tsaregorodtsev писал(а): | | Работы ЛеКуна брать в разделе публикаций на yann.lecun.com - там Вам нужно реально посмотреть только его большую обзорную работу 98 года по распознаванию рукописных символов (вынесена наверх странички в краткий список основных результатов), |
СПАСИБО!!!!!!! Пошел почитаю
| Victor G. Tsaregorodtsev писал(а): | | Но сразу предупреждаю, что готового софта нет и Вам придется эти сетки программировать с нуля в достаточно универсальном варианте (с возможностью управления числом слоев и т.д) для проведения экспериментов. |
если бы готовый стофт был, то и вопросов бы не возникло а если быть более точным - немного готового софта все же есть. В основном все ПО, существуемое в данной области работает на основе выделения градиентов, и, как показала практика использования данного ПО - процент ошибок очень большой....
| Victor G. Tsaregorodtsev писал(а): | | Т.е. если возникают трудности прямо на уровне алгоритма обратного распространения ошибки для обучения многослойного персептрона, то тогда лучше и не пытаться воспроизвести эти сверточные сетки. |
ээ... тут по подробней, если можно.... с тем персептроном, что я в первом посте привел, с обучением проблем нет (для тестов уже написан), но вот со сверточными сетями... немного почитал у Сайхмона, но, у него явно не достаточно информации... там достаточно бегло сверточные сети рассмотрены... или я уже подзабыл много... |
|
| Вернуться к началу |
|
 |
dns
Новый посетитель

Зарегистрирован: 24 Сен 2006
Сообщения: 9
|
 Добавлено: Пн Сен 25, 2006 8:51 am Заголовок сообщения: Re: Распознавание/классификация графических образов Добавлено: Пн Сен 25, 2006 8:51 am Заголовок сообщения: Re: Распознавание/классификация графических образов |
 |
|
| Victor G. Tsaregorodtsev писал(а): |
<погрызано>
|
Вчера вечером проанализировал возможность применения RBF алгоритмов. Тоже не катит. За ссылку на ЛеКуна спасибо, начал по тихому читать - видимо это именно то, что мне нужно, однако, тут все-таки с конгломератами вопрос остается.
Теоретически, сеть распознает и отсегментирует одну клетку на участве 30х30 пикселей, а остальные "спишет" на мусор... Вот тут как раз и вопрос - как узнать - на "кадре" конгломерат или одна клетка. Если конгломерат, то несколькопроходное сканирование делать с изменением центра картинки (только вот боюсь, что не поможет, т.к. в сети свертки имеет место быть автосегментатор)...
Вобщем, пока складывается впечатление, что без минимального препарсинга картинки не обойтись. Только что это будет за препарсинг - если честно, я в замешательстве.
P.S. Помощь любая приветствуется Проект "едет" на добровольных началах, но, для исследовательской лаборатории. Если все получится, как бонус - возможна публикация в центральной печати это пожалуй все, на что рассчитывать можно, т.к. гематология нынче в РФ не в почете (( Финансовое вознаграждение за помощь тоже возможно, но, не сильно большое, т.к. из собственного кармана платить буду. Т.к. для лабы - эта весч очень нужная, и, я готов на свое "хобби" личные средства потратить |
|
| Вернуться к началу |
|
 |
Victor G. Tsaregorodtsev
Эксперт

Зарегистрирован: 28 Июн 2005
Сообщения: 114
Откуда: Красноярск
|
 Добавлено: Пн Сен 25, 2006 9:11 am Заголовок сообщения: Re: Распознавание/классификация графических образов Добавлено: Пн Сен 25, 2006 9:11 am Заголовок сообщения: Re: Распознавание/классификация графических образов |
 |
|
| dns писал(а): | 1. в пределах одного класса клеток имеется достаточно "разброс" возможных вариантов того, как клетка будет выглядеть.
2. универсальность. При работе по яркости - мы строго привязываемся к определенному препарату, которым клетки окрашиваются (на разных препаратах разные "картинки" получаются)). Ну и под исследование попадают не только клетки человека, но и животных. Под микроскопом они по разному выглядят. Если у нас нейронка, то её можно "переобучить" на другой тип клеток, после чего "скармливать" снимки и делать обсчет...
|
Ну, тогда навскидку ничего простого и универсального предложить не могу, надо смотреть на снимки, вариабельность объектов на них и т.д. Да и после этого тоже, наверно, вряд ли получится обойтись без проверочных экспериментов и сразу найти-взять близкий к оптимальному вариант решения.
| dns писал(а): |
а где можно про этот фильтр почитать... к своему стыду не слышал про данные модели... а яндекс что-то ничего путного не ответил ISBN или название книжки, где почитать можно...
|
Моттль, Мучник "Скрытые марковские модели в структурном анализе сигналов", какое-то из центральных научных издательств (Наука или Физматлит) в районе 2000г. - это единственная книжка по этой теме, что у меня стоит на полке дома, и для которой я быстро выходные данные смогу привести при необходимости более детально. А так. конечно, по hidden markov models работ дофига, но надо просто тупо архивы просматривать.
| dns писал(а): |
спасибо, пойду почитаю. Я тут уже немного успел Саймона Хайкина почитать про сверточные сети, но, там что то мало написано про них
|
У Хайкина просто предельно недостаточное описание этих сетей
| dns писал(а): |
вот!!! именно по этому и решил на форуме проконсультироваться т.к. клетки располагаются в 3х мерном пространстве, то к камере они могут быть повернуты по любой из осей. В результате - обученная сетка (в моем первом посте) хорошо отрабатывает на отдельностоящих клетках и на клетках, которые очень похожи на те клетки, по которым сеть обучалась. А вот если показать сети ту же самую клетку, только повернутую на 30-40 град., то сетка "дохнет". В не повернутом варианте - клетка круглая (на снимке), в повернутом - соотв. овальная... Как раз по этому и родилась идея - использовать "предпроцессор", который будет бить изображение на секторы и внутри сектора производить некую обработку изображения, которое затем пойдет в обработку нейронкой.
|
Сверточные сетки относительно эффективно применялись (после стартовых работ ЛеКуна) для распознавания морд лица - но там не сильно большие углы поворота лиц. Это работа Steve Lawrence с соавторами года так 97. ЛеКун же перешел от распознавания рукописных символов на двумерной картинке к распознаванию именно трехмерных объектов - найдете там у него статью по этому поводу (я, к сожалению, даже по диагонали эту статью не смотрел).
С аффинными преобразованиями именно контуров распознаваемых объектов (повороты, растяжения по осям - как в указанном Вами случае превращения круга в эллипс) хорошо работает преобразование Хафа (Hough transform) - это способ сопоставления объекта с эталоном, поэтому сразу и написал про возможность выделения контуров фильтрами и затем работы с контурами.
| dns писал(а): | | ээ... тут по подробней, если можно.... с тем персептроном, что я в первом посте привел, с обучением проблем нет (для тестов уже написан) |
Имелось в виду именно программирование сеток - если простенькие бэкпроповские персептроны Вам будет сложно реализовать и довести (на Вашем объеме эталонных картинок) до быстрого и стабильного обучения (качество распознавания других, отличных от эталонных, картинок я пока не обсуждаю) - то сверточные сетки будете программировать и отлаживать еще дольше и преимущественно методом тыка (и советом никто не поможет - не ясно будет, либо это у Вас ошибка в коде, либо какое-то имманентное именно сверточным сеткам поведение именно в условиях Вашей задачи, и т.д. - т.е. тоже останется только гадать). Если же проблем в понимании, программировании и отладке нет - то можно и со сверточными сетками повозиться.
| dns писал(а): | | Вобщем, пока складывается впечатление, что без минимального препарсинга картинки не обойтись. Только что это будет за препарсинг - если честно, я в замешательстве. |
Черт его знает, я картинок не видел и даже чего-то прикидочного тоже не могу написать.
_________________
www.neuropro.ru - нейросети, анализ данных, прогнозирование |
|
| Вернуться к началу |
|
 |
dns
Новый посетитель

Зарегистрирован: 24 Сен 2006
Сообщения: 9
|
 Добавлено: Ср Сен 27, 2006 3:11 pm Заголовок сообщения: Re: Распознавание/классификация графических образов Добавлено: Ср Сен 27, 2006 3:11 pm Заголовок сообщения: Re: Распознавание/классификация графических образов |
 |
|
| Victor G. Tsaregorodtsev писал(а): |
Ну, тогда навскидку ничего простого и универсального предложить не могу, надо смотреть на снимки, вариабельность объектов на них и т.д. Да и после этого тоже, наверно, вряд ли получится обойтись без проверочных экспериментов и сразу найти-взять близкий к оптимальному вариант решения.
|
ок. как до лабы доберусь, попробую пример снимка скинуть, если интересно. А существуют ли какие-либо пакеты, что бы без программинга смоделировать работу той или иной архитектуры сети? Можно конечно самому написать под каждый тип сети свой код и затем прогонять исследуемый снимок, но, ИМХО, это очень длительный процесс (написание сети 1, отладка сети 1, тестирование на образце; написание сети 2, отладка сети 2, тестирование на образце... и т.д.)
| Victor G. Tsaregorodtsev писал(а): | | Моттль, Мучник "Скрытые марковские модели в структурном анализе сигналов" |
Спасибо! посмотрю. Я пока еще статью ЛеКуна перевариваю.....
| Victor G. Tsaregorodtsev писал(а): | | У Хайкина просто предельно недостаточное описание этих сетей |
ну вот (( зря деньги потратил....
| Victor G. Tsaregorodtsev писал(а): | | С аффинными преобразованиями именно контуров распознаваемых объектов (повороты, растяжения по осям - как в указанном Вами случае превращения круга в эллипс) хорошо работает преобразование Хафа (Hough transform) |
ок. попробую погуглить на эту тему. может что найти удастся. Что то мне по нейронкам катастрофически мало информации удаётся найти ( или не там ищу?
| Victor G. Tsaregorodtsev писал(а): | | то сверточные сетки будете программировать и отлаживать еще дольше и преимущественно методом тыка (и советом никто не поможет - не ясно будет, либо это у Вас ошибка в коде, либо какое-то имманентное именно сверточным сеткам поведение именно в условиях Вашей задачи, и т.д. - т.е. тоже останется только гадать). |
ну... я собственно изначально думал, что легко не будет
| Victor G. Tsaregorodtsev писал(а): | | Если же проблем в понимании, программировании и отладке нет - то можно и со сверточными сетками повозиться. |
тут есть одна проблема, но она больше из холивара, нежели понимания. Так вот, "проблема" в следующем: какой идеологии (технической) придерживаться при написании сети? Очень хочется использовать ООП, т.к. это красиво и, в общем-то, понятно... или же по натоптанной тропе процедурного программирования.... Т.к. опыт в написании сеток у меня можно сказать нулевой (всего один проект, что, имхо, катастрофически мало), в связи с этим и вопрос. |
|
| Вернуться к началу |
|
 |
Victor G. Tsaregorodtsev
Эксперт

Зарегистрирован: 28 Июн 2005
Сообщения: 114
Откуда: Красноярск
|
 Добавлено: Ср Сен 27, 2006 3:32 pm Заголовок сообщения: Re: Распознавание/классификация графических образов Добавлено: Ср Сен 27, 2006 3:32 pm Заголовок сообщения: Re: Распознавание/классификация графических образов |
 |
|
| dns писал(а): |
А существуют ли какие-либо пакеты, что бы без программинга смоделировать работу той или иной архитектуры сети?
|
Не помню более-менее мощного нейрософта, явно заточенного под работу с картинками. Может, NeuroSolutions что-то такое и умеет, но я не проверял.
Пакетов-то дофига. Statistica Neural Networks, NeuroSolutions, NeuroShell, российский Deductor наконец. В Матлабе Neural Networks Toolbox требует-таки программизма на матлабовском языке.
| Цитата: |
какой идеологии (технической) придерживаться при написании сети? Очень хочется использовать ООП, т.к. это красиво и, в общем-то, понятно... или же по натоптанной тропе процедурного программирования.... |
У меня все потроха сеток написаны исходно без ООП. Но я программистские удобства ставил на второй план. Рекомендация тут традиционная - берите самый удобный и беспроблемный (по прикидкам на будущее) вариант
_________________
www.neuropro.ru - нейросети, анализ данных, прогнозирование |
|
| Вернуться к началу |
|
 |
Eugeen
Эксперт

Зарегистрирован: 15 Ноя 2005
Сообщения: 66
Откуда: Москва
|
 Добавлено: Чт Сен 28, 2006 7:04 pm Заголовок сообщения: Re: Распознавание/классификация графических образов Добавлено: Чт Сен 28, 2006 7:04 pm Заголовок сообщения: Re: Распознавание/классификация графических образов |
 |
|
| Цитата: | Не помню более-менее мощного нейрософта, явно заточенного под работу с картинками. Может, NeuroSolutions что-то такое и умеет, но я не проверял.
Пакетов-то дофига,... NeuroSolutions, NeuroShell, российский Deductor наконец. В Матлабе Neural Networks Toolbox требует-таки программизма на матлабовском языке. |
NeuroSolutions не заточен под конкретику, хотя конечно это не студенческий Матлаб. Думаю что это один из самых серьезных пакетов по НС.
Еще, конечно, хочется попробовать сравнить его с Neural Works Pro/II, но пока денег не заработал на оба пакета.
Хотелось с кем нибудь поговорить про этот PRO/II.
Может кто его щупал?
_________________
Мелочи не играют решающей роли. Они решают все.
"Жизнь среди акул", Х. Маккей. |
|
| Вернуться к началу |
|
 |
dns
Новый посетитель

Зарегистрирован: 24 Сен 2006
Сообщения: 9
|
 Добавлено: Вт Ноя 07, 2006 9:23 am Заголовок сообщения: Re: Распознавание/классификация графических образов Добавлено: Вт Ноя 07, 2006 9:23 am Заголовок сообщения: Re: Распознавание/классификация графических образов |
 |
|
| Victor G. Tsaregorodtsev писал(а): | | У меня все потроха сеток написаны исходно без ООП. Но я программистские удобства ставил на второй план. Рекомендация тут традиционная - берите самый удобный и беспроблемный (по прикидкам на будущее) вариант |
Фух, наконец осилил несколько статей Ле Куна и еще пару книжков... Вобщем еще раз огромное спасибо, за то, что наставили "на путь истинный". К моему сожалению, вопросов стало только больше...
Ну, вопрос, какой идеологии придерживаться при написании, снят.
По марковским моделям информация очень скудная и я до сих пор не понял - могут они мне пригодиться или нет....
Вот что предстоит распознавать и классифицировать (это не очень хороший снимок, но, такие тоже будут.). Все клетки в одну сторону, ксе клетки с точками черными и просто черные точки - в другую. На этом работа нейронки заканчивается и начинается стат обработка.
Пример фотографии:

И еще - реально ли где-нибудь найти работающий исходник сверточной сети найти? В прочитанных мной статьсях описаны в основном общие принципы действия этих сетей... когдя я пытался хоть что-нибудь переложить на код.... в лучшем случае получался... не работающий алгоритм.... |
|
| Вернуться к началу |
|
 |
Oleg Agapkin
Администратор


Зарегистрирован: 10 Июн 2005
Сообщения: 112
Откуда: Москва
|
 Добавлено: Чт Ноя 09, 2006 6:59 pm Заголовок сообщения: Добавлено: Чт Ноя 09, 2006 6:59 pm Заголовок сообщения: |
 |
|
 Здесь речь идет о создании своего рода экспертной системы, которая будет ставить диагноз пациенту по снимку кровяного мазка? Указанная картинка похожа на снимок крови пациента с лейкемией. Здесь речь идет о создании своего рода экспертной системы, которая будет ставить диагноз пациенту по снимку кровяного мазка? Указанная картинка похожа на снимок крови пациента с лейкемией.
На мой взгляд, ввиду некоторой однородности картинки, имеет смысл изначально попробовать статистические (не нейросетевые) методы. Может быть, удасться классифицировать с наименьшими затратами.
Есть отличная книга - Методы компьютерной обработки изображений (Сайт издательства ФИЗМАТЛИТ, далее искать на сайте через поиск). Там же можно заказать ее через интернет. Человек, который занимается работой с изображениями обязательно найдет там много полезных методов анализа и предобработки графических данных.
Вот она же на Озоне, но значительно дороже. |
|
| Вернуться к началу |
|
 |
Oleg Agapkin
Администратор


Зарегистрирован: 10 Июн 2005
Сообщения: 112
Откуда: Москва
|
 Добавлено: Пт Ноя 10, 2006 12:38 pm Заголовок сообщения: Добавлено: Пт Ноя 10, 2006 12:38 pm Заголовок сообщения: |
 |
|
Почему бы не сделать что-нибудь типа этого:
Берется исходная картинка

Затем самым простым образом выделяются и пересчитываются черные точки и клетки с черными точками:

Потом убираем с исходного изображения области с черными точками

и любым градиентным (пороговым способом, выделением границ и пр.) выделяем и пересчитываем остальные клетки? |
|
| Вернуться к началу |
|
 |
dns
Новый посетитель

Зарегистрирован: 24 Сен 2006
Сообщения: 9
|
 Добавлено: Пт Ноя 10, 2006 1:29 pm Заголовок сообщения: Добавлено: Пт Ноя 10, 2006 1:29 pm Заголовок сообщения: |
 |
|
| Oleg Agapkin писал(а): |  Здесь речь идет о создании своего рода экспертной системы, которая будет ставить диагноз пациенту по снимку кровяного мазка? Здесь речь идет о создании своего рода экспертной системы, которая будет ставить диагноз пациенту по снимку кровяного мазка? |
нет, ставить диагноз не будет будет считать лейкоцитарную формулу показывать (как частный случай). Отобранные однородные клетки по признакам классифицировать.
Дело в том, что при подготовке крови (или любой иной клеточной субстанции) есть разные методики окраски (разные клеточки видно, цвета другие и т.д.).
Программа должна создавать галлерею клеток, т.е. мало их распознать, надо её еще из целевого снимка "выкусить" и засунуть в галлерею в соответствии с опознанным классом этой клетки.
Идея использования нейронки состоит в том, что бы можно было перенастраивать ПО под разные типы окраски без участия программиста. Ну и что бы при вводе очередного препарата можно было выбрать чем препарат окрашен, что бы программа использовала уже обученную сеть для распознавания.
Последний раз редактировалось: dns (Пт Ноя 10, 2006 1:33 pm), всего редактировалось 1 раз |
|
| Вернуться к началу |
|
 |
dns
Новый посетитель

Зарегистрирован: 24 Сен 2006
Сообщения: 9
|
 Добавлено: Пт Ноя 10, 2006 1:33 pm Заголовок сообщения: Добавлено: Пт Ноя 10, 2006 1:33 pm Заголовок сообщения: |
 |
|
| Oleg Agapkin писал(а): | Почему бы не сделать что-нибудь типа этого:
Берется исходная картинка
|
за пример огромное спасибо! Как я говорил, я сим делом уже лет как 5 не занимался, а тут вдруг понадобилось
Дело в том, что точки эти не всегда черные (все зависит от окраски), и не всегда есть, т.к. допустим у части клеток только оболочка есть, без ядра. А на других снимках, которые обсчитывать надо наоборот - клетки с ядрами. Есть снимки, где 2 вида клеток (без ядра и с ядром). Их нужно отобрать и отклассифицировать. Но тут, думаю тоде градиентный метод можно "прикрутить"... Вобщем - продолжаю думать...
Огромное спасибо за книжку. Обязательно куплю и изучу, т.к. очень мало пока удалось насобирать информации, а сделать предстоит много. |
|
| Вернуться к началу |
|
 |
Oleg Agapkin
Администратор


Зарегистрирован: 10 Июн 2005
Сообщения: 112
Откуда: Москва
|
 Добавлено: Пт Ноя 10, 2006 2:09 pm Заголовок сообщения: Добавлено: Пт Ноя 10, 2006 2:09 pm Заголовок сообщения: |
 |
|
Еще посмотрите вот этот пример. Это распознавание и классификация листьев с помощью нейронных сетей. С сайта можно скачать пример программы, там же есть описание методик. Может быть, этот пример тоже окажется полезным.  |
|
| Вернуться к началу |
|
 |
dns
Новый посетитель

Зарегистрирован: 24 Сен 2006
Сообщения: 9
|
 Добавлено: Пт Ноя 10, 2006 2:41 pm Заголовок сообщения: Добавлено: Пт Ноя 10, 2006 2:41 pm Заголовок сообщения: |
 |
|
интересно, наверное не подойдет, но пример очень интересный и часть информации от-туда все-таки полезна для моей работы Спасибо большое!
Книжку уже заказал, так что временно пропаду с форума, что бы потом появиться с новыми глупыми вопросами  если еще не надоел... если еще не надоел...  |
|
| Вернуться к началу |
|
 |
dns
Новый посетитель

Зарегистрирован: 24 Сен 2006
Сообщения: 9
|
 Добавлено: Вс Дек 10, 2006 1:26 pm Заголовок сообщения: Добавлено: Вс Дек 10, 2006 1:26 pm Заголовок сообщения: |
 |
|
приобрел еще книжку от физмата и бросился изучать. В итоге - "родилось" следующее представление способа решения проблемы:
1. Делаю пред-обработку изображения с целью выделить клеточки (тем же градиентным способом). Пока без классификации.
2. Определенные в п.1 области с клетками дробим на изображения и создаем галерею клеток.
3. При помощи нейронки пытаемся произвести классификацию картинок из галереи.
Плюсы (пока чисто умозрительно):
1. Градиентный метод работает быстрее, чем авто классификатор, построенный на нейронке
2. Меньший размер самой нейронки (т.к. оно дело проводить автосегментацию и классификацию при помощи нейронной сети, другое дело произвести сначала операцию сразу над всем изображением, что бы произвести выделение целевых областей картинки, а потом производить классификацию).
Минусы:
1. Не понятно, что делать с конгломератами... Есть подозрение, что градиентами их не разделить.... |
|
| Вернуться к началу |
|
 |
|
|
Вы не можете начинать темы
Вы не можете отвечать на сообщения
Вы не можете редактировать свои сообщения
Вы не можете удалять свои сообщения
Вы не можете голосовать в опросах
|
|